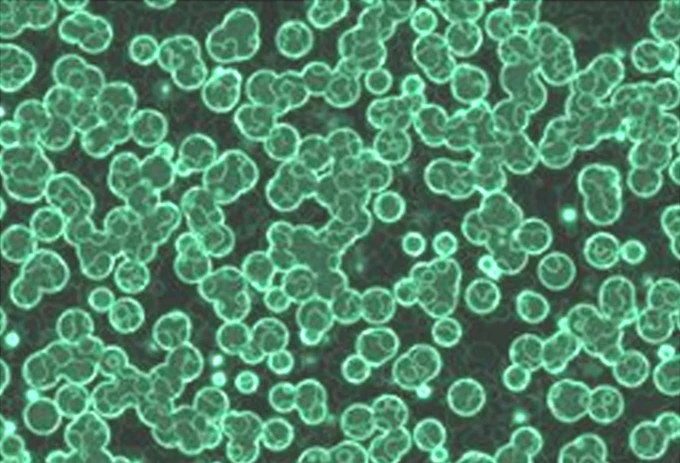
Nga phát triển công nghệ chiết xuất chất béo từ vi sinh vật

Một nghiên cứu từ Đại học Monash (Australia) vừa chứng minh, với sự hỗ trợ đúng cách, chính cơ thể con người có thể trở thành chiến binh mạnh mẽ chống lại ung thư, mang lại hy vọng cho các liệu pháp miễn dịch thế hệ mới.
![]() |
| Nghiên cứu mới do Đại học Monash và Công ty công nghệ sinh học oNKo-Innate (Melbourne, Australia) thực hiện mở ra hướng đi đầy hứa hẹn cho công cuộc điều trị ung thư. |
Thông tin từ Đại học Monash cho biết, một nghiên cứu từ Đại học Monash (Australia) vừa chứng minh, với sự hỗ trợ đúng cách, chính cơ thể con người có thể trở thành "chiến binh" mạnh mẽ chống lại ung thư, mang lại hy vọng cho các liệu pháp miễn dịch thế hệ mới.
Cơ thể con người vốn có một cơ chế phòng vệ tự nhiên chống lại ung thư, một yếu tố tăng trưởng có tên IL-15. Yếu tố này kích thích sản sinh các tế bào miễn dịch, trong đó có tế bào diệt tự nhiên (Natural Killer – NK), giúp phát hiện và tiêu diệt tế bào ung thư ngay từ khi chúng vừa hình thành.
Tuy nhiên, tế bào ung thư liên tục tiến hóa và phát triển các cơ chế tinh vi để "vô hiệu hóa" hệ miễn dịch, ngay cả trong môi trường giàu IL-15. Một hướng tiếp cận tưởng chừng hiệu quả là đưa vào cơ thể bệnh nhân các loại thuốc kích hoạt thụ thể IL-15 trên tế bào miễn dịch. Thế nhưng, các liệu pháp này lại gây độc tính nghiêm trọng vì chúng kích hoạt hệ miễn dịch trên toàn cơ thể, thay vì chỉ tại khối u, dẫn đến nhiều tác dụng phụ nặng nề.
![]() |
| Tế bào diệt tự nhiên NK giúp phát hiện và tiêu diệt tế bào ung thư ngay từ khi chúng vừa hình thành. |
Giờ đây, một nghiên cứu mới do Đại học Monash và công ty công nghệ sinh học oNKo-Innate (Melbourne, Australia) thực hiện đang mở ra hướng đi đầy hứa hẹn cho công cuộc điều trị ung thư.
Theo đó, nhóm nghiên cứu đã phát hiện một gene có thể “tắt” trong tế bào NK, giúp các tế bào này trở nên đặc biệt nhạy cảm với IL-15 nội sinh, từ đó thúc đẩy khả năng tiêu diệt ung thư hiệu quả hơn.
Nghiên cứu do Giáo sư Nick Huntington (Viện Nghiên cứu Y sinh Monash) và các cộng sự thực hiện, đã được công bố trên tạp chí quốc tế Cancer Cell. Nghiên cứu này cho thấy, khi loại bỏ gene này khỏi tế bào NK ở người, chỉ một lượng nhỏ IL-15 cũng đủ để kích hoạt mạnh mẽ khả năng tiêu diệt ung thư, giúp làm chậm sự phát triển của ung thư đại trực tràng trong mô hình tiền lâm sàng.
Điều đáng chú ý là gene này mã hóa một loại enzyme, nghĩa là nó hoàn toàn có thể bị ức chế bằng thuốc phân tử nhỏ. Trên thực tế, một loại thuốc đang được thử nghiệm để điều trị hội chứng rối loạn sinh tủy đã cho thấy khả năng can thiệp vào con đường phân tử tương tự, giúp tiêu diệt tế bào ung thư.
Giáo sư Huntington chia sẻ: “Điều này mang lại hy vọng về việc phát triển các loại thuốc đặc hiệu hơn, an toàn hơn để ứng dụng trong các trường hợp liệu pháp miễn dịch chưa tối ưu, cần tăng cường thêm phản ứng miễn dịch chống ung thư”.
![]() |
| Nghiên cứu do Giáo sư Nick Huntington (Viện Nghiên cứu Y sinh Monash) và các cộng sự thực hiện, |
Ở bệnh nhân ung thư đại trực tràng, các khối u thường tiết ra nhiều IL-15 hơn mô lành. Tuy nhiên, tế bào ung thư cũng có thể làm đột biến gen IL-15 để né tránh miễn dịch - đây là yếu tố thường liên quan đến nguy cơ tái phát và tiên lượng xấu. Việc tăng độ nhạy của tế bào miễn dịch với IL-15 nội sinh giúp kích hoạt phản ứng mạnh mẽ tại đúng vị trí khối u, đồng thời hạn chế ảnh hưởng đến các mô nơi IL-15 gần như không tồn tại.
Nhóm nghiên cứu đã sử dụng công nghệ CRISPR để sàng lọc và phát hiện các gene làm tăng độ nhạy của tế bào miễn dịch với yếu tố tăng trưởng. Kết quả cho thấy hai gene có thể bị loại bỏ trong các liệu pháp tế bào, hoặc bị ức chế bằng thuốc, từ đó cải thiện hiệu quả tiêu diệt ung thư của tế bào NK.
Theo ông Jai Rautela, Giám đốc điều hành oNKo-Innate, phát hiện này hoàn toàn có thể kết hợp với các liệu pháp miễn dịch hiện hành như ức chế điểm kiểm soát miễn dịch để tạo nên tác động cộng hưởng.
Ông khẳng định: “Thuốc tăng cường tín hiệu IL-15 có thể trở thành lớp phòng thủ bổ sung, giúp củng cố phản ứng miễn dịch ở những khối u trong giai đoạn tiến triển. Đây là minh chứng cho thấy, việc hiểu sâu về miễn dịch học có thể mang lại những đột phá trong việc giải quyết các bài toán sinh học khó khăn như IL-15, và mở đường cho thế hệ liệu pháp miễn dịch mới”.
Theo nhandan.vn

Thông tin bạn đọc
Đóng Lưu thông tin